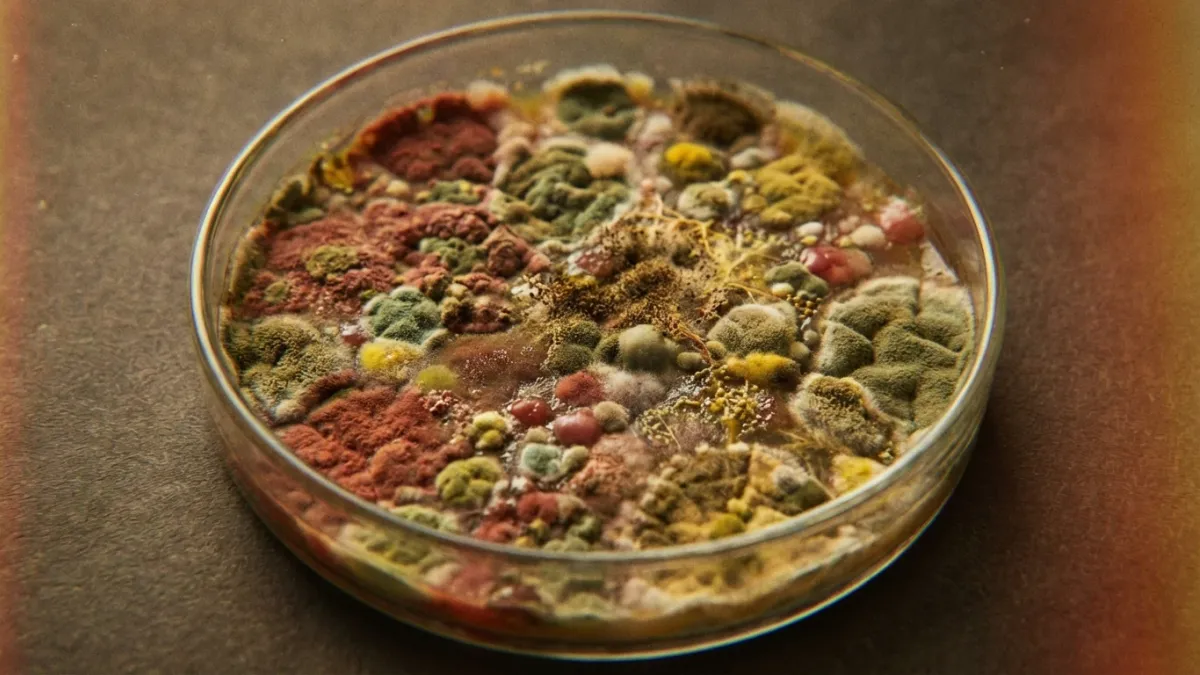

Deep Learning Model Detects Depression via Speech Patterns with 99% Accuracy
Researchers have developed a sophisticated artificial intelligence system capable of diagnosing depression solely by analysing voice recordings. By cleaning audio data and employing a specialised neural network optimized by a 'battle royale' algorithm, the method achieved a remarkable 99.26 per cent accuracy rate.
By Ashok Kumar, Domala, Sajjan, Bhadavath, Jadapalli, Vemula